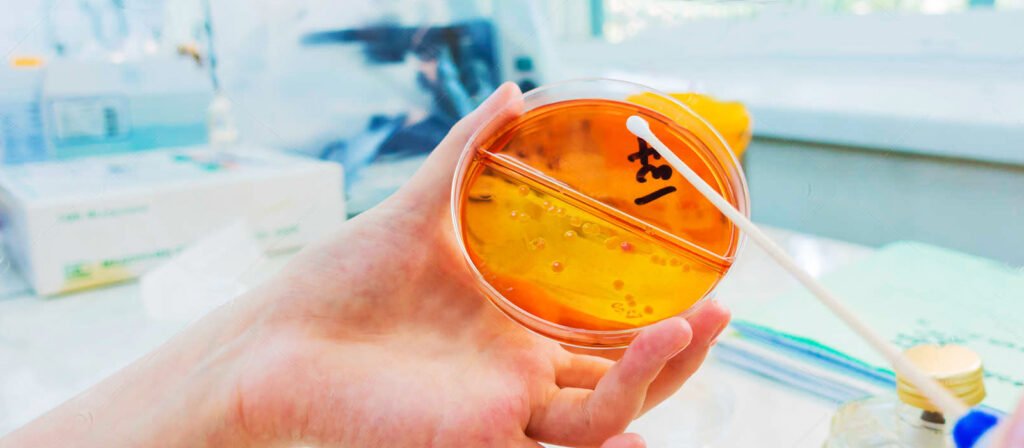

O que é um swab ? Como utilizá-lo corretamente?
Se você já precisou fazer algum exame laboratorial ou teve que coletar material biológico para análise, é provável que tenha ouvido falar do swab estéril. Mas afinal, o que é e para que serve esse pequeno objeto? Se ainda tem dúvidas sobre sua utilidade e importância em diferentes áreas da saúde, continue lendo este post e descubra tudo sobre o swab estéril!
O swab estéril é um dispositivo usado para coletar amostras biológicas, como material genético, células, bactérias e outros tipos de microrganismos.
Um “swab” é um pequeno instrumento utilizado principalmente para coletar amostras de tecido ou fluidos de partes do corpo para exames de diagnóstico. Comumente, os swabs são feitos de um material macio e absorvente, como algodão, fixado na ponta de uma haste de plástico ou madeira. Eles são usados em diversos contextos médicos, como na coleta de amostras de mucosa nasal para testes de COVID-19, na obtenção de amostras de células da garganta para testes de estreptococos, ou em exames ginecológicos para a coleta de células do colo do útero para exames de Papanicolau. Os swabs são projetados para serem descartáveis e são usados de forma a evitar a contaminação das amostras coletadas.
Ele consiste em um cabo longo composto por plástico ou madeira, e uma ponta que pode ser feita de algodão, espuma ou até mesmo feltro. Essa ponta é absorvente e possui a capacidade de capturar as amostras sem contaminar a cultura celular. Além disso, o swab é descartável e resistente à água, permitindo que seja armazenado em condições ideais para exames posteriores.
Para que serve um Swab?
Os swabs estéreis são usados para coletar amostras de tecido ou fluidos corporais para exames laboratoriais. Eles também podem ser usados para limpar feridas ou áreas infectadas.
Um swab é utilizado para coletar amostras de tecido ou fluidos de diversas partes do corpo para análise diagnóstica. Suas principais aplicações incluem:
- Diagnóstico de Infecções: Swabs são frequentemente usados para coletar amostras de mucosa nasal, garganta, ouvido, ou pele para testar a presença de vírus (como o SARS-CoV-2, causador da COVID-19), bactérias, ou outros patógenos.
- Exames Ginecológicos: Em ginecologia, swabs são usados para coletar amostras do colo do útero para testes de Papanicolau, que ajudam a detectar alterações celulares pré-cancerosas ou cancerígenas.
- Testes de DNA: swabs bucais são usados para coletar células da boca para testes de DNA, que podem ser usados em testes de paternidade, análise genética ou pesquisa criminal.
- Culturas Bacterianas: São utilizados para coletar amostras para culturas bacterianas, ajudando a identificar infecções bacterianas e determinar a sensibilidade a antibióticos.
- Limpeza Médica: Em alguns casos, swabs podem ser usados para aplicar medicamentos, limpar feridas ou realizar pequenos procedimentos de limpeza.
Cada tipo de swab é projetado para um uso específico, garantindo a coleta eficiente e segura de amostras sem contaminá-las ou causar danos ao tecido.
Como usar um Swab?
O uso correto de um swab depende do tipo de amostra que está sendo coletada e da área do corpo de onde ela será obtida. Aqui estão algumas diretrizes gerais para diferentes tipos de coleta de amostras com um swab:
- Swab Nasal (como para testes de COVID-19):
- Lave as mãos com água e sabão ou use um desinfetante para as mãos.
- Retire o swab da embalagem sem tocar na ponta de algodão.
- Incline levemente a cabeça para trás.
- Insira a ponta do swab em uma das narinas (geralmente até cerca de 2 cm ou conforme indicado nas instruções).
- Gire o swab suavemente contra a parede interna da narina, geralmente por alguns segundos.
- Repita no outro lado, se necessário, usando o mesmo swab.
- Retire o swab e o insira na embalagem de transporte sem tocar em outras superfícies.
- Swab de Garganta:
- Abra a boca e diga “Ahh” para expor a garganta.
- Use uma lanterna, se necessário, para visualizar as amígdalas.
- Insira o swab sem tocar na língua, lábios ou dentes.
- Esfregue o swab nas amígdalas e na parede posterior da
garganta, evitando tocar na língua ou nos lábios.
- Retire o swab sem tocar em outras superfícies e coloque-o na embalagem de transporte.
- Swab Bucal (para testes de DNA):
- Antes de coletar a amostra, evite comer, beber, fumar, ou mastigar chiclete por pelo menos 30 minutos.
- Abra a embalagem do swab sem tocar a ponta.
- Passe o swab na parte interna da bochecha, girando-o e esfregando-o contra a bochecha várias vezes para coletar células da mucosa.
- Repita o processo com um novo swab na outra bochecha, se necessário.
- Coloque o swab de volta na embalagem sem contaminá-lo.
- Swab Uretral ou Vaginal:
- Este procedimento é normalmente realizado por um profissional de saúde, pois requer técnicas específicas para evitar contaminação e garantir a coleta adequada de amostras.
Em todos os casos, é crucial seguir as instruções específicas fornecidas com o kit de coleta de swab ou as diretrizes do profissional de saúde. Após a coleta, a amostra deve ser manipulada e transportada de acordo com as instruções para garantir a sua validade. Lembre-se também de manter uma boa higiene, lavando as mãos antes e após a coleta da amostra.

O Swab é considerado eficaz para a coleta de amostras?
Sim, o swab é considerado eficaz para a coleta de amostras em muitas situações, especialmente em contextos médicos e laboratoriais. Aqui estão algumas razões pelas quais o swab é eficaz:
- Facilidade de Uso: Swabs são fáceis de usar e permitem a coleta de amostras de locais específicos do corpo, como nariz, garganta, pele ou superfícies.
- Minimamente Invasivo: A coleta com swab é geralmente menos invasiva e desconfortável em comparação com outras técnicas de coleta de amostras, como biópsias.
- Ampla Aplicabilidade: Swabs podem ser usados para coletar amostras para uma variedade de testes, incluindo testes de DNA, culturas bacterianas, testes virais (como COVID-19), e testes de contaminação ambiental.
- Segurança: Os swabs são frequentemente esterilizados e embalados individualmente, reduzindo o risco de contaminação cruzada.
- Precisão: Quando usados corretamente, os swabs podem coletar uma quantidade suficiente de material biológico para análises precisas.
- Portabilidade: Swabs são pequenos e portáteis, facilitando a coleta de amostras em campo ou em ambientes onde o transporte de equipamento volumoso seria difícil.
É importante seguir as diretrizes de coleta e manuseio de amostras específicas para cada tipo de teste para garantir a eficácia e precisão dos resultados obtidos com o uso de swabs.
Conclusão
O swab estéril é um dispositivo médico que é usado para coletar amostras de secreções ou outros fluidos do corpo para fins de exame. É feito de um material absorbente, como algodão, que está envolvido em uma ponta de um bastão de plástico. A outra extremidade do bastão tem um gancho que pode ser usado para segurar o swab durante a coleta da amostra
Os Swab ou suabes estéreis são ferramentas essenciais para muitos tipos de processos farmacêuticos, laboratoriais e outros procedimentos relacionados à saúde. Podem ser usados tanto para a obtenção de amostra quanto para limpar ou esterilizar áreas do corpo em preparação para uma cirurgia ou tratamento.
Cada tipo de swab é específico para sua aplicação, garantindo a coleta eficaz e segura da amostra necessária para o diagnóstico correto. É importante usar o tipo correto de swab para cada procedimento para obter resultados precisos.
Solicite seu orçamento em swab.
Participe do nosso blog, envie seu comentário, dúvida ou sugestão.
AVISO DE DIREITOS AUTORAIS: Todo o material deste blog, sendo proibida toda e qualquer forma de plágio, cópia, reprodução ou qualquer outra forma de uso.
Qualquer dúvida técnica sobre os equipamentos contidos no portfólio SPLABOR, entre em contato com o Departamento de Vendas (sp@splabor.com.br)

A Splabor é uma empresa líder no ramo de fabricação de equipamentos para laboratório, especializada em oferecer uma ampla variedade de equipamentos para laboratórios, materiais e produtos para laboratório de alta qualidade.